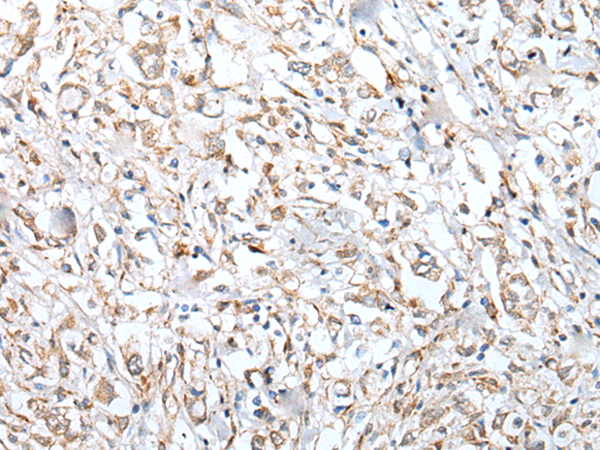

|
Background: |
The protein encoded by this gene is the human ortholog of the mouse VpreB3 (8HS20) protein, is thought to be involved in B-cell maturation, and may play a role in assembly of the pre-B cell receptor (pre-BCR). While the role of this protein in B-cell development has not yet been elucidated, studies with the chicken ortholog of this protein have found that when overexpressed, this protein localizes to the endoplasmic reticulum. The mouse ortholog of this protein has been shown to associate with membrane mu heavy chains early in the course of pre-B cell receptor biosynthesis. Expression of this gene has been observed in some lymphomas. |
|
Applications: |
ELISA, IHC |
|
Name of antibody: |
VPREB3 |
|
Immunogen: |
Fusion protein of human VPREB3 |
|
Full name: |
pre-B lymphocyte 3 |
|
Synonyms: |
8HS20; N27C7-2 |
|
SwissProt: |
Q9UKI3 |
|
ELISA Recommended dilution: |
5000-10000 |
|
IHC positive control: |
Human cervical cancer |
|
IHC Recommend dilution: |
25-100 |
購物車
購物車 幫助
幫助
 021-54845833/15800441009
021-54845833/15800441009
